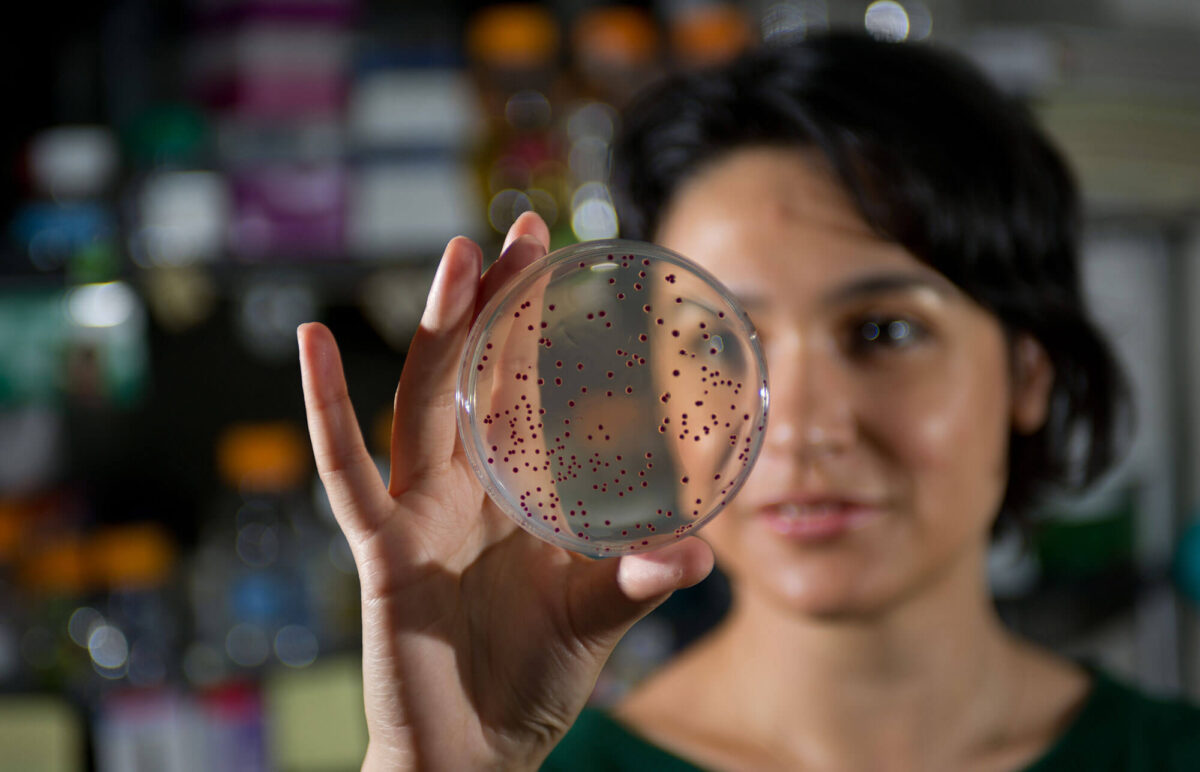

Science Square will become a regional and global hub for bioscience and life science that will draw research and investment from both academia and private industry regionally and nationally. By focusing on the discovery and development of tools that contribute to humanity and improve the human condition, Science Square will be the preeminent hub for scientific discovery.